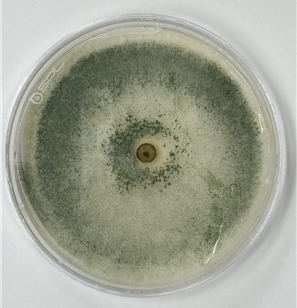

시판되는 상처치료제보다 치료효과가 약 2배 높은 천연 상처치료물질을 국내 연구진이 찾아냈다.
환경부 산하 국립호남권생물자원관이 전북 부안군 바닷가에서 확보한 곰팡이 성분으로 상처 치료제(하이드로겔) 샘플을 개발했다고 15일 밝혔다.
이번에 개발된 상처 치료제는 곰팡이에서 유래한 펩타이드(알라메티신) 및 키토산 등의 상처 치료용 천연물질이 포함됐으며, 기존 항생제 내성균 군집을 87% 감소시키는 효과가 확인됐다. 상처 치유 활성 실험 결과, 시중 제품 대비 약 1.96배의 빠른 상처 회복 효과가 나타났다.
연구에 사용된 곰팡이인 'Trichoderma viride'는 식물병 원인균 억제와 식물 성장 촉진에 도움을 주는 곰팡이로, 이 곰팡이에서 추출된 항균 펩타이드인 알라메티신은 항생제나 항균제에 저항성을 보이는 감염 치료 연구에 활용되고 있다.
이번 개발은 국립호남권생물자원관(섬야생생물소재 선진화연구단)이 2023년부터 진행 중인 '다부처 국가생명연구자원 선진화사업(환경부 과제)'의 일환으로 추진됐으며, 전남대학교 약학대학 조남기 교수 연구진과 공동으로 수행됐다.
연구진은 이번 연구결과에 대해 올 9월 특허를 출원했으며, 앞으로 세균 감염 관리 및 상처 치유 촉진을 위한 의약(외)품 개발 후속 연구를 확대할 계획이다.
최경민 국립호남권생물자원관 섬야생생물소재선진화연구단장은 "이번 연구는 섬과 연안의 생물 자원을 활용하여 지속가능한 바이오 소재 개발에 기여할 수 있는 성과"라며 "상처 치료용 의약품과 화장품 등 다양한 산업적인 활용 가능성을 적극 검토하고 있다"고 밝혔다.
Copyright @ NEWSTREE All rights reserved.

- 김나윤 기자 jamini2010@ 다른기사보기